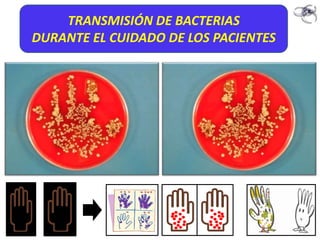
TRANSMISIÓN DE BACTERIAS
DURANTE EL CUIDADO DE LOS PACIENTES

Este documento describe los principios básicos de bioseguridad en el ámbito de la salud, incluyendo la transmisión de agentes infecciosos, reservorios, barreras de protección, limpieza y desinfección, residuos peligrosos, y equipos de protección personal. En resumen, explica cómo prevenir y controlar la propagación de infecciones en entornos médicos a través de medidas universales de higiene.